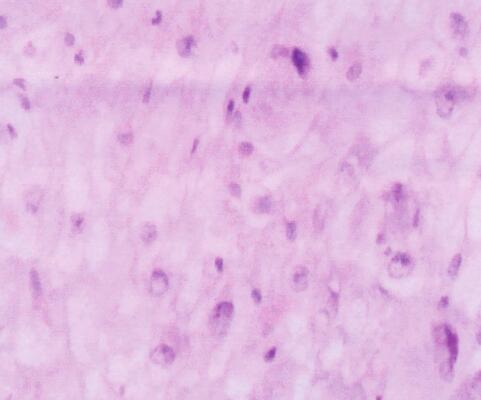

老爷爷反复咳嗽咳痰、气短15年 近来症状逐渐加重
73岁男性,反复咳嗽、咳痰及气短症状15年,冬季好发,每年发病大于3个月,迁延不愈,呈逐年加重趋势,自行吸氧及吸入硫酸沙丁胺醇气雾剂后气短症状有缓解,未住院系统诊治。1年来自觉喘息症状逐渐加重,严重影响日常活动,需卧床休息或吸入硫酸沙丁胺醇气雾剂后可缓解。1个月前上述症状再次发作,发病前无明显诱因,吸入硫酸沙丁胺醇气雾剂后疗效不佳,自觉发热,但未测体温,上述症状逐渐加重,遂来笔者医院就诊。该患者患有……
患者男性,73岁,于2010年3月31日入院。
一、主诉
反复咳嗽、咳痰、喘息15年,加重1年,再发1个月。
二、病史询问
(一)初步诊断思路及问诊目的
患者高龄,反复发作咳嗽、咳痰、喘息,冬季好发,每年持续3个月以上,迁延不愈,逐年加重,发作时吸入硫酸沙丁胺醇气雾剂后喘息症状有所缓解,既往长期吸烟史,根据患者高龄及病情介绍,将慢性阻塞性肺疾病放在首位。因此,问诊目的主要围绕慢性阻塞性肺疾病的发病诱因,主要症状及特点、持续时间,伴随症状,院外治疗情况等,同时注意与其他相关疾病鉴别。
(二)问诊主要内容及目的
1.是否有吸烟史,量是多少,发病前是否有受凉、感冒等诱因?
慢性阻塞性肺疾病患者多有长期吸烟史,吸烟量较大,或有职业粉尘及化学物质接触史,常于感冒、受凉时诱发,感染及劳累等因素所致的机体免疫功能低下也是其常见诱因。
2.咳嗽是否伴有咳痰,痰液颜色及性状,是否有咯血或痰中带血,是否伴有发热?
如咳嗽,咳黄色黏痰多考虑由感染所致,如同时伴有发热则更支持感染。另外患者高龄,长期吸烟,如有咯血或痰中带血,应注意肿瘤的可能性。
3.病初是否每年均出现咳嗽、咳痰及气短症状,每次持续多长时间,是否进行性加重?
多数慢性阻塞性肺疾病患者每年于季节交替气温变化时发病,每年发病持续约3个月或以上,迁延不愈,并呈逐年加重趋势。
4.曾经是否到医院就诊、明确诊断及治疗,此次入院前是否应用了药物对症治疗?什么药?症状是否缓解?
通过了解是否曾到医院明确诊治,对此次患者就诊了解患者病情方面有很大帮助。了解院外对症治疗的情况以及患者症状是否缓解,来进一步评估患者疾病进展情况,并分析药物的选择是否合理等问题,同时为入院后药物选择提供参考。
5.既往有何种基础疾病,是否有呼吸系统症状?
某些慢性基础疾病如糖尿病可导致感染机会增加,可能加速慢性阻塞性肺疾病进展,甚至可能是其迁延不愈的重要因素,了解既往基础疾病及用药情况有助于初始经验性治疗药物的选择,还要询问呼吸困难是否平卧加重或有夜间憋醒的表现,以鉴别心源性因素所致呼吸困难。
6.职业暴露,粉尘、毒物及放射性物质接触史等。
许多呼吸系统疾病与职业暴露因素相关,如翻砂、电焊等。
(三)问诊结果及临床分析
患者曾为政府职员,平时无粉尘、毒物及化学物质接触史。既往吸烟30余年,平均每天约30支,无心脑血管疾病及糖尿病病史。反复发作咳嗽、咳痰及气短症状15年,冬季好发,每年发病大于3个月,迁延不愈,呈逐年加重趋势,自行吸氧及吸入硫酸沙丁胺醇气雾剂后气短症状有缓解,未住院系统诊治。1年来自觉喘息症状逐渐加重,严重影响日常活动,需卧床休息或吸入硫酸沙丁胺醇气雾剂后可缓解,1个月前上述症状再次发作,发病前无明显诱因,曾外出散步但未觉受凉,咳嗽,咳白黏痰,痰黏不易咳出,无咯血及痰中带血,气短明显,轻微活动后加重,可平卧,无夜间阵发性呼吸困难。吸入硫酸沙丁胺醇气雾剂后疗效不佳,自觉发热,但未测体温,上述症状逐渐加重遂来诊。
【临床分析】
通过问诊可明确,患者既往吸烟30余年,已戒10年,无其他基础疾病。反复发作咳嗽、咳痰及气短15年,未就医系统诊治,本次发病自觉发热,但未测体温,结合患者高龄,慢性咳嗽、咳痰、气短病史,近来饮食睡眠欠佳,体重下降,考虑免疫功能较常人下降,本次发病感染诱发可能性大,应在体格检查时重点注意肺部听诊是否存在啰音,并通过相关检查寻找感染证据。患者可平卧,无夜间阵发性呼吸困难,口服氨茶碱及吸入硫酸沙丁胺醇气雾剂后气短症状可缓解,心源性因素可能性不大。
三、体格检查
(一)重点检查内容和目的
考虑患者本次发病呼吸道感染诱因可能性大,对患者进行系统全面查体,注意准确测量体温,注意肺部体征,尤其是啰音。患者高龄,长期吸烟史,还应注意周身浅表淋巴结有无肿大,注意鉴别肿瘤疾病,注意心脏查体,与心源性疾病相鉴别。
(二)体格检查结果及临床分析
体温37.7℃,呼吸20次/分,脉搏96次/分,血压120/80mmHg。神志清楚,呼吸略促,被迫平卧位,周身浅表淋巴结未触及,口唇略发绀,气管居中,无三凹征,桶状胸,胸廓对称,肋间隙增宽,双侧呼吸运动一致,双肺叩诊呈过清音,双肺散在哮鸣音,右下肺少许小水泡音,心界不大,心音纯,律齐,各瓣膜听诊区未闻及杂音,腹部、四肢、神经等系统检查均未见异常。
【临床分析】体格检查结果与问诊后初步考虑与慢性阻塞性肺疾病急性加重的思路相吻合。体温37.7℃,双肺散在干鸣音,右下肺少许小水泡音提示以感染为诱因导致了慢性阻塞性肺疾病急性加重,双肺哮鸣音表明气道痉挛、狭窄或内有分泌物阻塞气道所致。心脏查体未见异常不支持心源性疾病。进一步行实验室和影像学检查的主要目的是明确病变部位、病原学,并判断病情,为治疗方案提供依据。
评价:结合上述问诊及查体结果,已初步了解了患者的疾病发展,针对该患者制定初步诊疗方案,在此基础上进行全面细致的辅助检查,有利于更好的评估病情,以进一步完善诊治计划。
四、实验室和影像学检查
(一)初步检查内容及目的
1.血常规、C-反应蛋白、降钙素原:
进一步证实患者有无感染。
2.血清支原体、衣原体、军团菌抗体检查:
明确病原。
3.痰菌涂片、痰培养、尿培养:
明确病原。
4.动脉血气分析、肺功能:
评价病情。
5.胸部影像学:
明确诊断并了解病变部位和范围。
(二)检查结果及临床分析
【检查结果】
1.血常规:白细胞计数13.97×109/L,中性粒细胞百分比86.9%,淋巴细胞百分比11.8%,红细胞计数4.59×1012/L,血红蛋白120g/L,血小板计数527×109/L。C-反应蛋白:明显升高。
2.血清支原体、衣原体、军团菌抗体均阴性。
3.痰菌涂片(-),痰培养、尿培养:待三天后出结果。
4.动脉血气分析(吸氧中):pH 7.47,PaO2 117mmHg,PaCO2 36mmHg。
5.肺功能FEV1/FVC为59%,FEV1占预计值为48%,重度阻塞性通气功能障碍,支气管舒张试验阴性。
6.胸部CT:双肺下叶、右肺上叶可见斑片状高密度影,左肺可见团块状高密度影,分界不清,CT值20HU。
【临床分析】
根据检查结果回报:①末梢血白细胞计数、中性粒细胞百分比及CRP均明显增高;②肺功能示重度阻塞性通气功能障碍,支气管舒张试验阴性;胸部影像学示双肺炎性改变,左肺可见团块状高密度影,分界不清,CT值20HU。;结合患者的病史和体格检查结果,考虑为感染所致慢性阻塞性肺疾病急性加重、左肺下叶占位性病变,目前病原学尚不明确,患者发病以来未系统用药治疗,病史长,反复发作,肺功能示重度阻塞性通气功能障碍,双肺炎性改变,说明患者慢性阻塞性肺疾病病情重,加之此次感染,炎症已累及多肺叶,通气功能进行性下降,患者自觉呼吸困难。进一步的处理应是立即选择合适的抗感染药物进行治疗,同时进一步完善肺部肿瘤相关检查,治疗感染的同时,进一步明确诊断。
五、治疗方案及理由
【方案】
哌拉西林钠/他唑巴坦钠3.375g,每日2次,静脉滴注;甲泼尼龙40mg,每日2次,静脉滴注;多索茶碱0.3g,每日1次,静脉滴注;盐酸氨溴索30mg,每日2次,静脉滴注;吸入用复方异丙托溴铵溶液2.5ml+吸入用布地奈德混悬液2ml,每日2次,雾化吸入。
【理由】
感染所致慢性阻塞性肺疾病急性加重的患者在初始治疗时尚无微生物学检查依据,根据患者高龄,既往基础疾病,本次发病的临床表现及目前检查结果回报给予经验性抗感染治疗,考虑患者以杆菌感染为主,哌拉西林钠/他唑巴坦钠可覆盖杆菌,同时对厌氧菌也有效,并且对染色体β-内酰胺酶稳定,根据慢性阻塞性肺疾病诊治指南,给予相应抗感染、解痉平喘、化痰等对症治疗。
六、治疗效果及临床分析
(一)治疗效果
经哌拉西林钠/他唑巴坦钠坦抗感染治疗体温较前降低,咳嗽咳痰及呼吸困难症状较前有所缓解,双肺啰音较前减少,患者左胸部疼痛,自觉与呼吸相关。在此期间实验室检查结果:①血常规白细胞总数及中性粒细胞百分比较前下降;②血清各种抗体(支原体、衣原体、军团菌)仍阴性;③痰菌培养:肺炎克雷伯杆菌(3次);④胸部CT:双肺斑片状高密度影较前略有吸收,但左肺团块影仍存在(图1A肺窗、B纵隔窗)。

图1
(二)临床分析
给予患者初始经验治疗后,综合评估肺部炎症较前缓解,但有胸痛且与呼吸相关,考虑与肺部病灶累及胸膜有关,或与其他因素,如肺部占位病变有关,应进一步完善肿瘤相关化验检查,肿瘤病理检查,明确病灶性质,同时可评估患者是否存在胸骨转移导致患者胸痛。还应继续询问患者病史,以掌握更多的临床证据。
评价:原本认为根据指南给予相应治疗后患者症状可以缓解,但事实相反,患者症状缓解不明显,肺部病灶未见吸收,需要考虑是经验性治疗错误还是药物覆盖不够;但患者自觉胸痛难忍,应用止痛药物缓解不明显,结合患者既往长期吸烟史,近期消瘦,为了明确上述问题,尽快完善肿瘤相关检查。
七、再问病史和实验室检查结果
通过再次深入询问病史较前无差异,本次入院后胸痛逐渐加重,给予止痛药物后不缓解。完善肿瘤系列、痰查瘤细胞,是否存在肿瘤因素。肿瘤系列:AFP 5.1μg/L(<10μg/L),CEA 38.6μg/L(<10μg/L),CA199 72.0U/ml(0~37U/ml),CA125 151.2U/ml(0~30U/ml),PSA 1.12ng/ml(<4.0ng/ml)。结果显示CEA、CA199、CA125均有不同程度升高,以CEA及CA125升高最为明显。痰查瘤细胞:镜下未见瘤细胞。同时完善经皮肺活检,病理提示恶性肿瘤,提示恶性间皮瘤(图2)。
图2
补充上述资料后,答案揭晓,为恶性肿瘤,近来消瘦,饮食欠佳,既往有基础疾病史,加之本次感染打击,致免疫功能低下,恶性肿瘤疾病进展,最终导致患者症状无明显缓解。
八、调整治疗方案及疗效
继续给予抗感染对症治疗,同时结合患者影像学及病理结果进行肿瘤分期,制定合理的化疗方案,给予化疗,肺部感染症状较前缓解,血感染指标较前下降,胸痛症状逐渐消失,但患者高龄,基础状态差,免疫功能低下等导致对化疗的耐受程度低,仅完成第一阶段化疗。
【最终诊断】
恶性胸膜间皮瘤 慢性阻塞性肺疾病急性加重期
九、对本病例误诊误治的思考
胸膜间皮瘤是主要的胸膜原发肿瘤,发病率较低,仅占所有胸膜肿瘤的5%,包括良性和恶性胸膜间皮瘤,其中后者更常见。多数病人发病前有石棉接触史,潜伏期35~40年。起病隐匿,症状没有特异性,容易漏诊。持续性胸痛是最常见的症状,甚至是本病早期的唯一症状,疼痛呈持续性,与呼吸无关,随着病程进展,胸痛逐渐加重。晚期胸痛剧烈,影响睡眠和饮食,一般镇痛剂难以缓解。呼吸困难是胸膜间皮瘤的另一种常见症状,随着疾病进展逐渐加重。影像学检查可发现胸膜不规则增厚或突入胸腔的块状增厚,极少数患者影像学表现为肺部阴影,本患者病灶位于左肺,与典型影像学不符,这也是导致误诊的一个重要原因,故保持对本病的警惕及影像学的变化的掌握尤为重要。对于该患者,病程中无明确的石棉接触史,故亦导致误诊。丰富临床经验,加强对疾病的掌握是非常重要的。
该例患者被误诊考虑有如下原因:首先,恶性胸膜间皮瘤发病率低,临床比较少见,因此临床医师对此类疾病诊治经验少,常常是惯性思维,纠结于常见病及多发病,忽略此病的诊断,常误诊为肺炎等,导致一些重要的实验室检查被遗漏;其次,该疾病临床症状不典型,多无特异性临床表现;第三,该病胸部影像学表现多样,胸部X线及CT上多表现为胸腔积液及胸膜肥厚,有的也可表现为肺部团块影,所以极易误诊为胸膜炎、肺癌或胸膜转移癌等疾病;由于上述因素,加之临床医生对该疾病经验不足,知识掌握不全面,导致该疾病与其他相关疾病不易鉴别,尤其是疾病早期更容易误诊,因此临床医生提高对该疾病的认识,提高业务水平,加强对疾病全面掌握,对影像学结果认真判读是尤为重要的。
综上所述,本病例误诊误治关键点是:①对胸膜间皮瘤这种罕见病认识不足;②实验室检查缺乏特异性,未进行及时全面的检查。
小贴士
恶性胸膜间皮瘤的X线表现
根据X线表现可分为3型:
1.胸腔积液型;
2.不规则胸膜增厚型;
3.孤立肿块型。
沈阳医学院附属中心医院 夏书月 郑爽
(环球医学编辑:余霞霞)
来源:《防范与走出常见诊疗误区:呼吸疾病临床病例精粹》
作者:康健
页码:154-159
出版:人民卫生出版社
- 评价此内容
- 我要打分
近期推荐
热门关键词
合作伙伴
Copyright g-medon.com All Rights Reserved 环球医学资讯 未经授权请勿转载!
网络实名:环球医学:京ICP备08004413号-2
关于我们|
我们的服务|版权及责任声明|联系我们
互联网药品信息服务资格证书(京)-经营性-2017-0027
互联网医疗保健信息服务复核同意书 京卫计网审[2015]第0344号




会员登录

